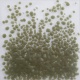
FF/4 Opalina Gris 3025 1 KG

Carrito: 0 producto Productos vacío
Ningún producto
0,00 € Impuestos
0,00 € Total
Producto añadido correctamente a su carrito de la compra
Cantidad
Total
Hay 0 artículos en su carrito. Hay 1 artículo en su cesta.
Total productos:
Impuestos 0,00 €
Total
Vidrio Optul COE 82 Para Float
- Libros
- Vidrios Varios
- Vidrio System 96
- Vidrio Wissmach
- Oceanside Compatible COE 96
- Vidrio de Murano COE 104
- Vidrio Float, Fusing
- Flosing Glass
- Vidrio Bullseye COE 90
- Vidrio Moldeado y Tubos
- Vidrios Minibiselados
- Minibiselados Cuadrados
- Minibiselados Rectángulos
- Minibiselados Triángulos
- Minibiselados Círculos
- Minibiselados Prismas
- Minibiselados Esquinas
- Minibiselados Rombos
- Minibiselados Polígonos
- Minibiselados Medios Círculos
- Minibiselados Ovalos
- Minibiselados Estrellas
- Minibiselados Arcos
- Minibiselados Cuartos Círculos
- Minibiselados Conjuntos
- Minibiselados Decorados
- Vidrio Lamberts
- Protección y Sujeción
- Herramientas de Corte
- Vidrio Uroboros
- Herramientas de Pulido
- Herramientas de Ensamblar
- Artículos de Ensamblar
- Iluminación
- Vidrio Caliente
- Artículos para Fusing
- Pintura Caliente
- Vidrio Optul COE 82 Para Float
- Decoración en Frío
- Joyería y Bisutería
- Muestrarios y Lotes
- Suministros para Cristalerías
- Maquinaria segunda mano
Más
Este artículo se vende en envases de un kilo y de 250grms.
Este artículo tiene un COE de +/- 82 y es para fundirlo con vidrio Float industrial.
Aunque tiene un porcentaje muy alto de compatibilidad con el vidrio Float, siempre es recomendable hacer un test de compatibilidad antes de hacer el trabajo definitivo, así evitaremos sorpresas y frustraciones.
El color que veremos en el envase de estos artículos puede que no se presente siempre del mismo color y que no se parezca en nada al de despues de fundido.
Para que tenga una visión de cual será el color final despues de fundido observe el cuadrado de color en la fotografía y también la fotografía del vidrio fundido.
El color real después de fundido puede diferir un poco de la fotografía aquí mostrada.
Dentro de un mismo color puede que su tono y transparencia después de fundido no sea el mismo en todos los grosores de los granos.
Un color puede cambiar su tono y transparencia después de fundido dependiendo del grosor de la capa aplicada.
Siempre es recomendable aplicar este producto por la cara no estañada del vidrio Float para que todas las piezas de un mismo proyecto salgan con el mismo tono.
Siempre es recomendable hacer una prueba de color antes de hacer el trabajo final.
Siempre es recomendable que todo el vidrio Float industrial de base que vayamos a usar en un mismo proyecto sea de la misma procedencia.
Este artículo tiene un COE de +/- 82 y es para fundirlo con vidrio Float industrial.
Aunque tiene un porcentaje muy alto de compatibilidad con el vidrio Float, siempre es recomendable hacer un test de compatibilidad antes de hacer el trabajo definitivo, así evitaremos sorpresas y frustraciones.
El color que veremos en el envase de estos artículos puede que no se presente siempre del mismo color y que no se parezca en nada al de despues de fundido.
Para que tenga una visión de cual será el color final despues de fundido observe el cuadrado de color en la fotografía y también la fotografía del vidrio fundido.
El color real después de fundido puede diferir un poco de la fotografía aquí mostrada.
Dentro de un mismo color puede que su tono y transparencia después de fundido no sea el mismo en todos los grosores de los granos.
Un color puede cambiar su tono y transparencia después de fundido dependiendo del grosor de la capa aplicada.
Siempre es recomendable aplicar este producto por la cara no estañada del vidrio Float para que todas las piezas de un mismo proyecto salgan con el mismo tono.
Siempre es recomendable hacer una prueba de color antes de hacer el trabajo final.
Siempre es recomendable que todo el vidrio Float industrial de base que vayamos a usar en un mismo proyecto sea de la misma procedencia.